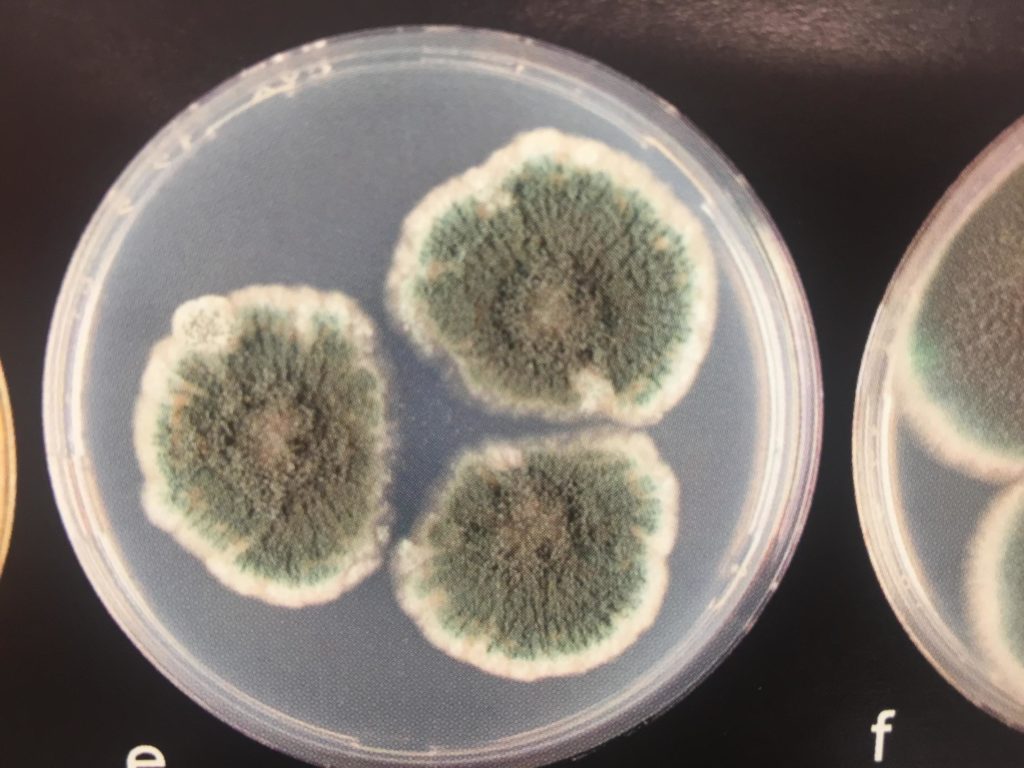

The integrity of any analysis starts with sampling. While extracts and infused products are straightforward since composition is usually homogeneous, sampling of a whole or part plant is challenging. Even within the same plant, the cannabinoid and terpene profile will vary tremendously; the top of the plant, the bottom of the plant, the leaves, and the stalks will have different cannabinoid content and ratios. For this reason, an appropriate sampling plan is essential to ensure that the tested material is a reasonable representation of the whole batch.
Our validated methods use molecular biology techniques to minimize the amount of materials needed for analysis.
Stillwater Laboratories offers sample pickup throughout Montana as part of our general service, with no minimum number of samples. Drop-offs during normal business hours are always welcome.

Foreign Matter Inspection is your first assurance of product quality. Stillwater Labs starts by examining your sample by microscope to determine the type and amount of foreign material in your sample to ensure that the cannabis meets foreign material standards. Minimal amounts of foreign material such as debris, fibers, and even naturally occurring molds are expected in agricultural products; current regulations also call for fewer than 5% stems that are greater than 3mm (1/8”) in diameter and less than 2% seeds; any large stems or seeds are partitioned and weighed as part of the inspection. No mammalian feces are allowed in Montana’s medical cannabis, astonishing in if only for the fact that this must be stated.
As part of the examination, photos are taken and added to your analysis report and data folder on your secure folder. The collection of images is your property and available for marketing, study, or distribution.

Potency testing is essential for an effective therapy. There are over 150 cannabinoids (THC and CBD are two of the most active) whose concentrations vary by plant species, the location on the plant, the environment it was grown in, the time of harvest, and storage post-harvest. Stillwater Labs’ potency testing provides you with percentages of the important cannabinoids in your sample. This profile allows the patient to select the most appropriate product for their therapy and to determine the correct dosage.
Stillwater Labs currently tests for eleven common cannabinoids:

Terpenes are an added dimension to MMJ. Although terpenes do not fall under Montana’s MMJ Act, terpenes are the compounds that give cannabis its flavor and character. The terpene profile is also thought to modify the effects of cannabinoids and is therefore a characteristic that patients often consider when purchasing cannabis. At Stillwater Labs, the Terpene Profile is generated using a special device to capture volatile compounds; we then identify and determine the concentrations of these materials and include this information in the report.
Currently Stillwater Laboratories analyze for the following terpenes:
On request, we would be pleased to add additional terpenes to your report.

Moisture content affects the storage and susceptibility of prepared cannabis to molds and bacterial growth. Moisture content below 15% discourages microbe growth; above 15%, care should be taken to ensure that no bacterial or fungal growth occurs and follow-up testing is recommended. To ensure that no molds are likely to grow post-harvest, Montana regulations call for no more than 12% moisture in plant material; as a naturally low-humidity state, this is rarely an issue with dried and stored flower.
Stillwater Labs uses Shimadzu MOC63u Moisture Balances, which provides a precise accelerated drying schedule and a microbalance to determine the weight of water in a sample. While this is part of our routine analysis of flower, if you wish to purchase a balance for your own on-site real-time tests during drying please contact us or Shimadzu and we would be pleased to provide you with details.
Moisture analysis is not required for extracts, tinctures, or edibles (infused products).

Stillwater Labs can provide fast identification of pathogenic microbes. Microbes are common in nearly all agricultural products due to natural dispersal in our environment. Most of these are not a cause for concern, but some are known pathogens and may pose a health risk. Stillwater Labs uses a validated commercial method to identify E. Coli and Salmonella sp. within 48 hours. Current action limits for E. coli and Salmonella are 10 CFU (colony forming units) per gram.
Stillwater Labs also uses quantitative polymerase chain reaction (qPCR) methods to rapidly identify pathogenic bacteria, often same-day. In addition, we can identify common molds using this technique. Please ask for additional information.

Stillwater Labs tests for a wide range of pesticides. Pesticides are commonly used agricultural tools that allow the grower to maximize the growth and character of cannabis plants. However, some residual pesticides that are considered safe for agricultural use may be harmful when combusted and ingested as a vapor.
Pesticide testing is the most difficult of the analytical methods (and the most expensive). The lab must detect very minute quantities of materials in a noisy matrix, and with over 500 commercially available pesticides, separation and precision are a challenge. Stillwater Labs has developed methods that use state-of-the-art chromatography and mass spectrometry to determine the concentration of pesticides that are designated by the state, plus many others.
The following 18 pesticides and action limits are required by Montana’s MMJ Act:
Of note, when extracting cannabinoids, pesticides can be concentrated preferentially, up to 13X more than the cannabinoids. Also, pesticides may reside in higher concentrations on the leaves than flower, so the use of trim in an extraction batch may lead to much higher concentrations of pesticides than that seen in the mother flower. For this reason, testing of extracts, even with fully characterized starter flower, is required.

Mycotoxins are highly carcinogenic compounds that are produced by certain species of Aspergillis molds. The mycotoxins of concern are aflatoxin B1, B2, G1, G2, and Ochratoxin A. Allowable action limits are 20ppb (parts per billion) of combined aflatoxin and 20ppb of Ochratoxin A.
Stillwater Labs uses chromatography to separate mycotoxins from background materials and a very sensitive form of mass spectroscopy to identify them.
Some solvents used for extracts add additional testing requirements. Extracts of the cannabis plants use water, organic solvents, or super-critical carbon dioxide to separate the cannabinoids and terpenes from the inactive plant matter. Some solvents such as water, ethanol or super-critical carbon dioxide are not restricted, but residual hydrocarbons other than ethanol may be a concern, particularly trace amounts of potential carcinogens such as benzene and chloroform.
Analysis for the following fifteen solvents are required by Montana’s MMJ Act:
Solvents are often easily evaporated and therefore pose problems in analysis. Stillwater Labs uses a special device to capture volatile compounds to ensure that these materials are recovered and identified.
